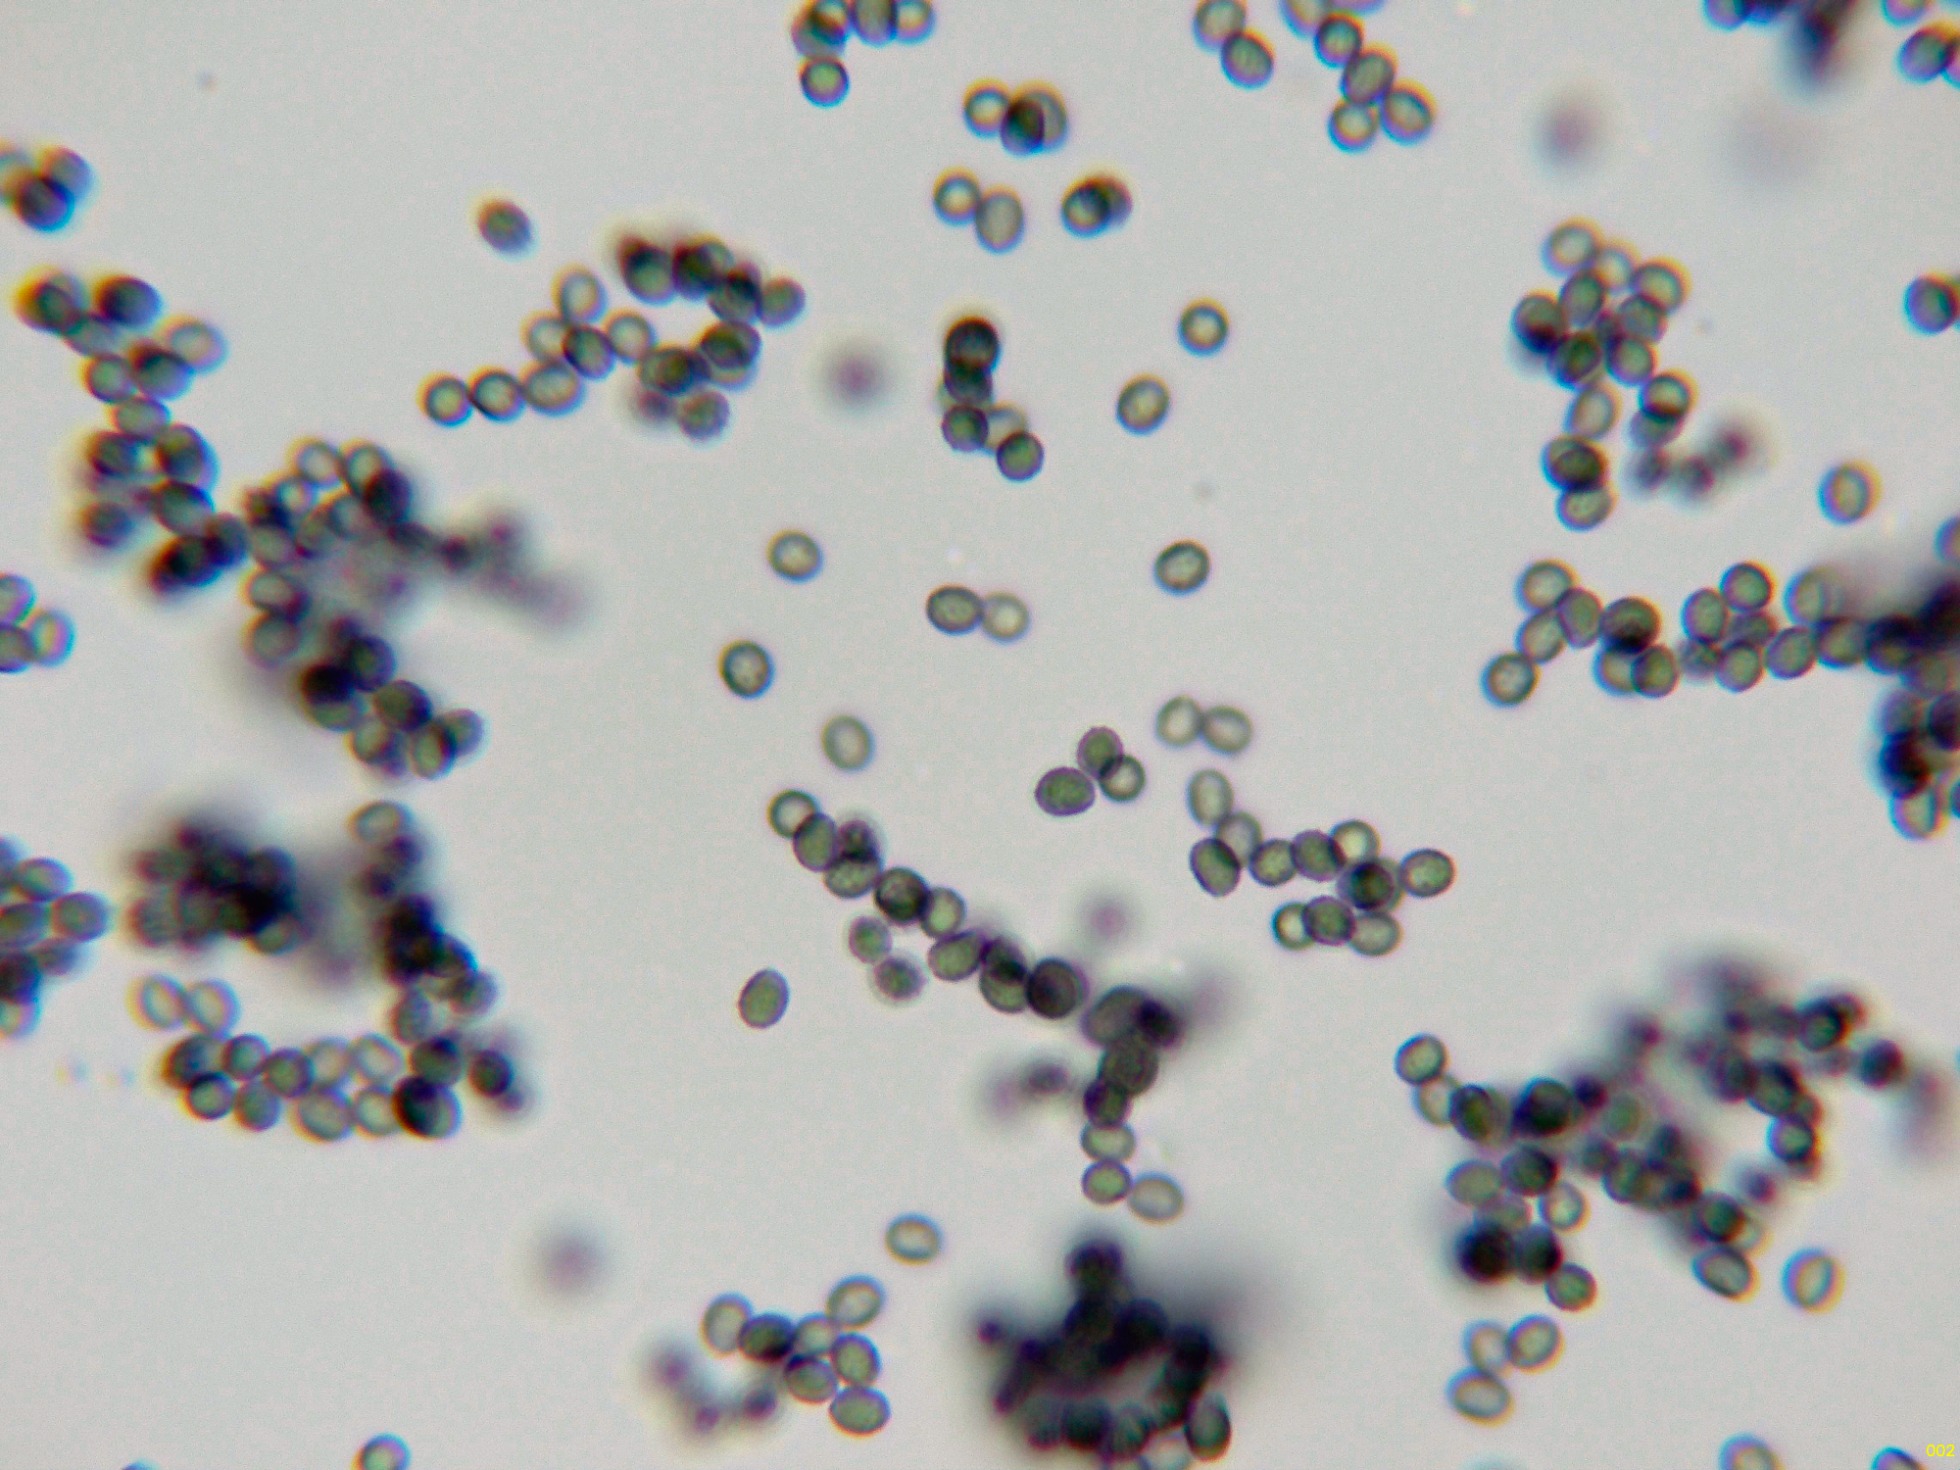
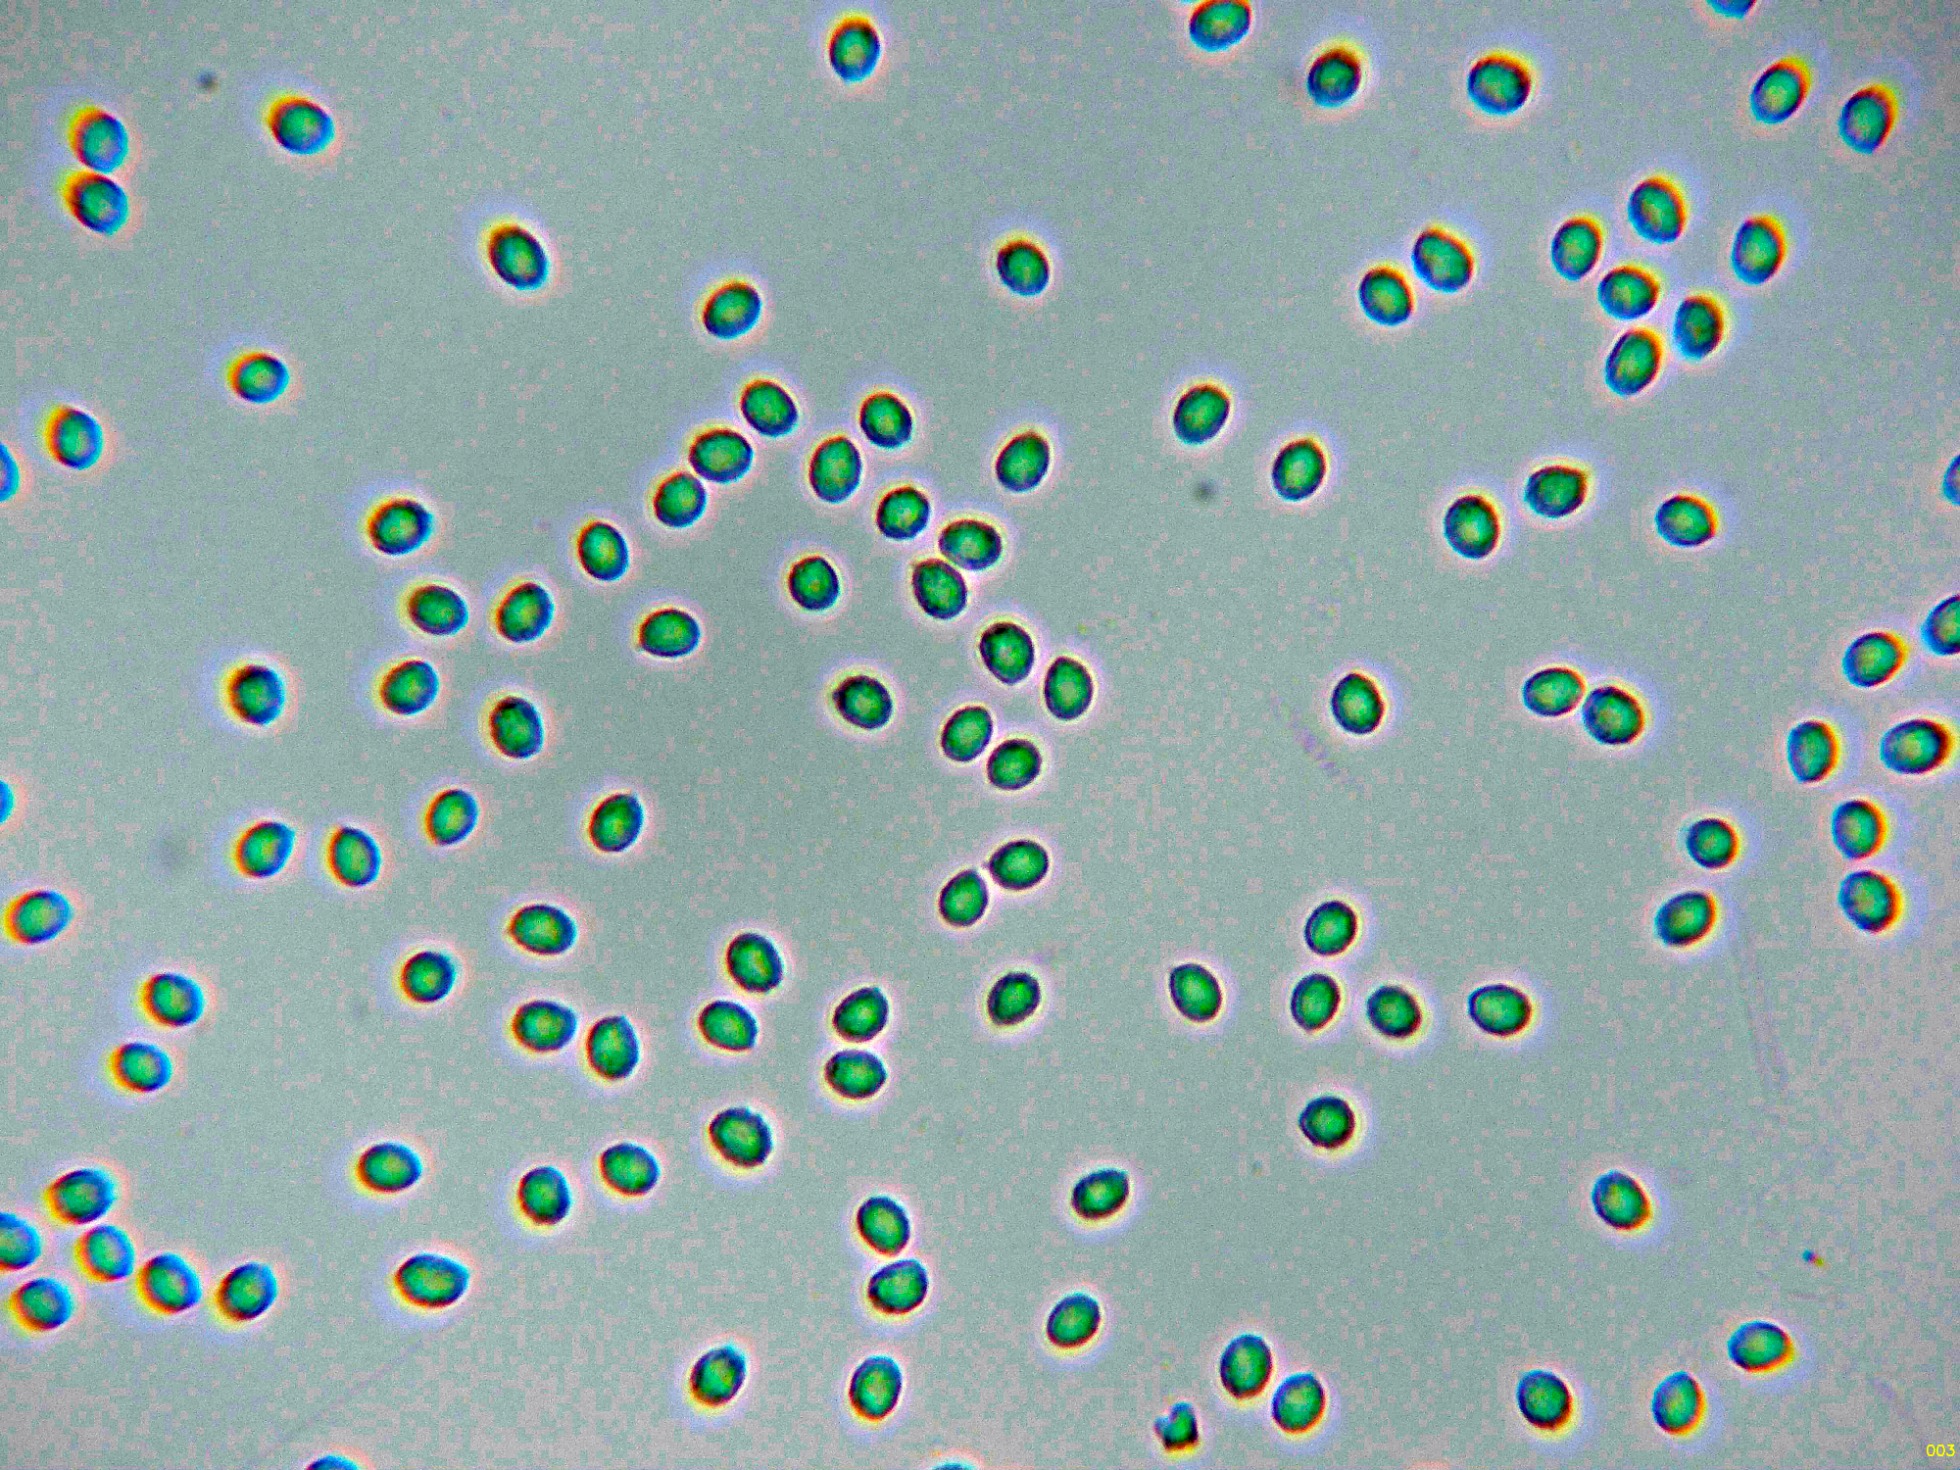

- Foro
- Foros sobre Micología de fungipedia
- Microscopía
- Gloeocystidiellum porosum (Berk. & M.A. Curtis) Donk. Microscopía.
 Gloeocystidiellum porosum (Berk. & M.A. Curtis) Donk. Microscopía.
Gloeocystidiellum porosum (Berk. & M.A. Curtis) Donk. Microscopía.
- Josep Torres
-
 Autor del tema
Autor del tema
- Fuera de línea
- Moderador
-

Menos
Más
- Mensajes: 8746
- Gracias recibidas: 8379
1 año 9 meses antes #110045
por Josep Torres
Hola a tod@s.
Un Corticial de aspecto céreo, de color crema fotografiado el 19 de mayo pasado, brotando sobre la superficie descortezada de un tronco tumbado del suelo de planifolio.
Gloeocystidiellum porosum (Berk. & M.A. Curtis) Donk
Superficie del basidioma a 20 aumentos.
Cistidios ahusados abundantes en el himenio, con contenido en su interior (gloeocistidios).
Los basidios tetraspóricos.
Las esporas en Reactivo de Melzer, con un comportamiento claramente amiloide.
Las esporas en agua, minuciosamente verrucosas, con verrugas difíciles de observar con el microscopio óptico.
Estas esporas obtenidas por esporulación natural y en agua con unas medidas de:
(4) 4.1 - 4.7 (4.8) × (3.1) 3.2 - 3.6 (3.7) µm
Q = (1.1) 1.2 - 1.3 (1.4) ; N = 40
Me = 4.4 × 3.4 µm ; Qe = 1.3
Saludos a tod@s.
Un Corticial de aspecto céreo, de color crema fotografiado el 19 de mayo pasado, brotando sobre la superficie descortezada de un tronco tumbado del suelo de planifolio.
Gloeocystidiellum porosum (Berk. & M.A. Curtis) Donk
Superficie del basidioma a 20 aumentos.
Cistidios ahusados abundantes en el himenio, con contenido en su interior (gloeocistidios).
Los basidios tetraspóricos.
Las esporas en Reactivo de Melzer, con un comportamiento claramente amiloide.
Las esporas en agua, minuciosamente verrucosas, con verrugas difíciles de observar con el microscopio óptico.
Estas esporas obtenidas por esporulación natural y en agua con unas medidas de:
(4) 4.1 - 4.7 (4.8) × (3.1) 3.2 - 3.6 (3.7) µm
Q = (1.1) 1.2 - 1.3 (1.4) ; N = 40
Me = 4.4 × 3.4 µm ; Qe = 1.3
Saludos a tod@s.
Adjuntos:
Por favor, Identificarse para unirse a la conversación.
- Foro
- Foros sobre Micología de fungipedia
- Microscopía
- Gloeocystidiellum porosum (Berk. & M.A. Curtis) Donk. Microscopía.
Tiempo de carga de la página: 0.069 segundos

Foro de micología